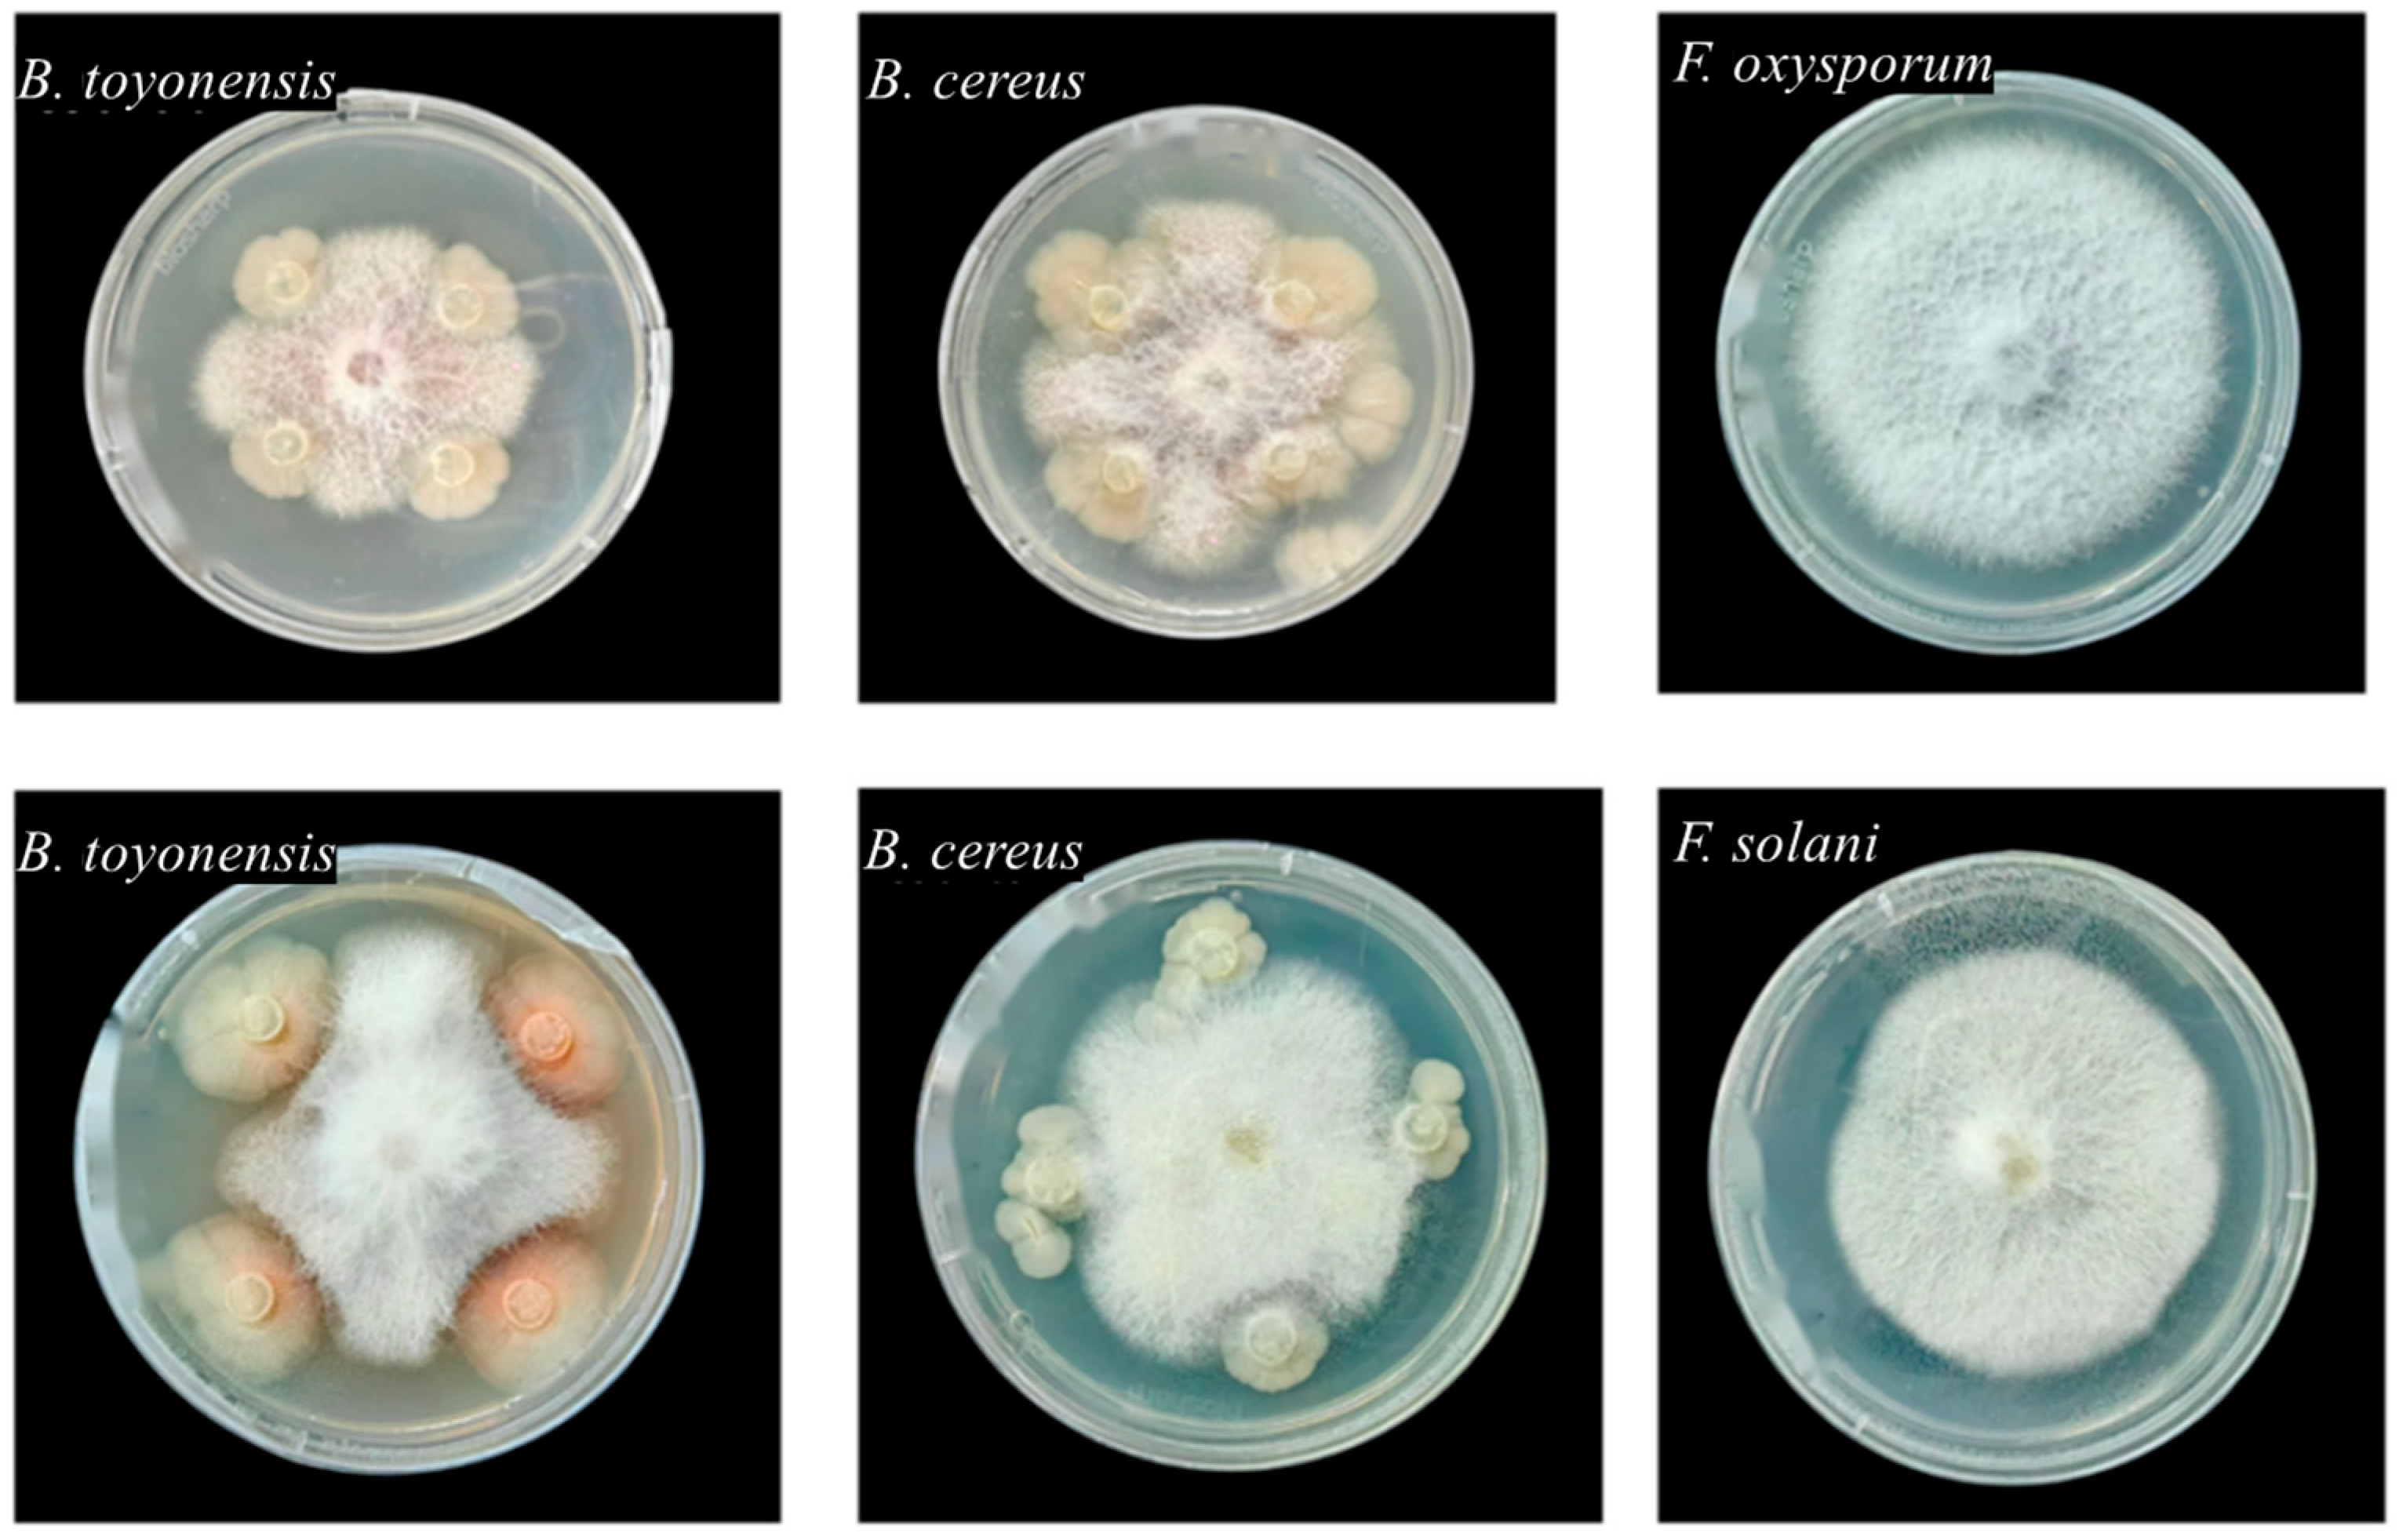
Horticulturae 11 01162 g0a2

1. Introduction
Plant endophytes refer to microorganisms—including bacteria, fungi, and actinomycetes—that colonize plant tissues without causing apparent disease symptoms [
1,
2]. They are ubiquitously distributed in various plant organs such as roots, stems, leaves, flowers, fruits, and seeds [
2]. The symbiotic relationships between endophytes and their host plants range from mutualism to commensalism, contributing significantly to plant growth, development, and adaptation to environmental stresses [
3]. Through mutualistic interactions with their hosts, these microbes participate in plant growth promotion, disease suppression, and stress resistance enhancement [
4], playing a crucial role in plant–soil ecosystems [
5,
6].
Among these, seed endophytes (SEs), as the initial source of the plant microbiome, not only exhibit high diversity but also serve as key regulators of seedling establishment and plant health [
7,
8]. Due to their significant effects and unique transmission mode, seed endophytes (SEs) serve as a critical complement to the host’s genetic traits. However, traditional research has predominantly focused on soil or mature plant endophytic communities, often overlooking the unique ecological characteristics of “individual seeds” as independent microecosystems—particularly the host-specific functions of seed-transmitted endophytes and their long-term effects on seedling health. Consequently, deciphering the structure and function of seed endophytic communities, especially identifying core seed-transmitted endophytes with biocontrol potential, holds significant promise for developing microbial fertilizers and reducing reliance on chemical pesticides [
9,
10].
Panax notoginseng (Burk.) F.H. Chen, a perennial medicinal herb of the Araliaceae family, is renowned for its hematopoietic, anti-inflammatory, antioxidant, and anti-aging properties [
11]. Native to China and predominantly cultivated in Yunnan and Guangxi provinces, its large-scale production faces severe threats from root rot disease caused by
Fusarium spp. [
12,
13,
14]. While chemical control remains the primary management strategy, concerns over pesticide residues and ecological risks have spurred interest in endophyte-mediated biocontrol as a sustainable alternative [
15]. Although previous studies have characterized endophytic communities in
P. notoginseng plants, the structure and function of SEs—particularly inter-individual heterogeneity and their antagonistic potential against common pathogens
Fusarium spp.—remain unexplored [
16]. A deeper understanding of the antagonistic activities and plant-growth-promoting capacities of seed-originating microbes could provide new insights into integrated disease management strategies for this economically important medicinal species.
In this study, we focused on single-plant-derived seeds of 3-year-old
P. notoginseng from Wenshan Prefecture, Yunnan Province. Using high-throughput sequencing, we characterized the seed endophytic microbiome at the individual seed level, capturing intra-species homogeneity and heterogeneity, and overcoming the limitations associated with bulk sample analyses [
17,
18]. Furthermore, we isolated culturable endophytic bacteria from seeds and evaluated their antagonistic activity against
Fusarium spp. pathogens. The most promising isolates were subsequently assessed for their ability to promote plant growth and suppress disease in seedling assays. The key innovations of this work include (i) profiling the endophytic community structure of individual
P. notoginseng seeds, (ii) identifying core taxonomical and functional members involved in host–microbe interactions, and (iii) establishing a direct link between seed-derived beneficial bacteria and resistance to root rot disease. Our findings provide valuable endophytic resources for the development of eco-friendly biocontrol agents and contribute to a theoretical framework for leveraging seed-transmitted microbiomes in the sustainable cultivation of medicinal plants.
4. Discussion
This study demonstrates that
P. notoginseng seeds host a rich endophytic microbial community, dominated by the fungal phyla Ascomycota and Basidiomycota and the bacterial phyla Firmicutes and Proteobacteria—a profile consistent with those documented in other plant species [
3]. Core microbiota analysis revealed conserved structural patterns across individual seeds, with a highly stable core microbiome constituting over 90% of the sequencing reads, a distribution congruent with prior observations in
Plantago lanceolata seeds [
34]. And accumulating evidence supports that core microbial taxa maintain compositionally conserved profiles across generational cycles, accounting for more than 90% of total microbial abundance [
34,
35,
36]. These findings indicate that the seed endophytic microbiome possesses strong transgenerational stability, suggesting its potential role as an epigenetic element in host plants [
3]. This heritable stability likely stems from a mutually beneficial symbiosis established through prolonged co-evolution between the host and its microbial partners [
3]. Moreover, we observed a dose-dependent accumulation of microbial diversity with increasing sample size, implying that larger seed pools serve as more diverse microbial inocula for progeny. This enhanced inoculum diversity may contribute to improved ecological adaptability in offspring through microbiome-mediated phenotypic modulation. Thus, deciphering the mechanisms underlying the heritability of seed endophytes and their co-evolutionary trajectory with hosts is essential for advancing our understanding of plant-microbe symbioses. These insights may ultimately inform strategies for microbiome-driven crop enhancement and sustainable agricultural practices [
37].
Core bacterial and fungal taxa exhibit closer associations with the host plant compared to other microbial groups. Notably,
Bacillus,
Halomonas, and
Shewanella were identified as the dominant seed-transmitted bacterial genera, while
Aspergillus predominated among seed-associated fungi [
38]. A spore-forming bacterial strain (BS3) isolated from maize sprouts demonstrated plant growth-promoting effects and enhanced resistance against
Fusarium verticillioides in infested soils [
38]. A study on tomato seed endophytes characterized the
Bacillus community using 16S rRNA gene PCR-RFLP (restriction fragment length polymorphism) analysis across four commercial cultivars. The
B. subtilis strain HYT-12-1 exhibited significant growth-promoting activity in tomato seedlings, highlighting its potential for industrial application as a biofertilizer [
39]. Functional studies of endophytic bacteria in
Platycodon grandiflorus revealed that
Luteibacter sp. JG09 efficiently biotransforms protopanaxadiol-type ginsenosides (Rb1, Rb2, Rc, Rd) into rare ginsenosides F2 and C-K, while converting protopanaxatriol-type ginsenoside Rg1 to Rh1 [
40]. The bacterial genus
Burkholderia-Caballeronia-Paraburkholderia consistently ranked among the top 5 most abundant taxa (7.82–18.01%) across 5 seed samples. This genus, along with core endophytes
Massilia and
Dyella, has been implicated in the regulation of continuous cropping obstacles [
41]. These bacteria modulate the production of carbamic acid derivatives (N-(2-butyl)-N-octadecyl ethyl ester) and soil metabolites in
Gastrodia elata cultivation systems, which may serve as initial triggers for replant disease [
41]. Intriguingly, orobanchol levels showed significant correlation with the relative abundance of phosphate-solubilizing
Burkholderia-Caballeronia-Paraburkholderia, while 4-deoxyorobanchol was associated with
Dyella and
Umbelopsis species [
42]. Agronomic practices such as maize-peanut rotation significantly enhance crop productivity, with
Burkholderia-Caballeronia-Paraburkholderia emerging as both a dominant and indicator genus in the critical 20–40 cm soil layer. This microbial group demonstrates detoxification capabilities against peanut-derived autotoxins and provides protection against soil-borne pathogens [
43]. These findings collectively demonstrate that
P. notoginseng seeds harbor diverse endophytic bacterial communities containing multiple taxa with beneficial functional traits. Further investigation is warranted to explore the agricultural potential of these probiotic microorganisms in
P. notoginseng cultivation systems.
SEs play a crucial yet often overlooked role in the classical “disease triangle” framework (encompassing plant, pathogen, and environmental factors). The exploration of disease-resistant resources within seed endophytes holds significant potential for green prevention strategies and modern agricultural practices. With studies revealing that rice plants of the same cultivar can differentiate into resistant and susceptible phenotypes [
44,
45,
46], and
Sphingomonas melonis accumulates in disease-resistant rice seeds and demonstrates transgenerational transmission, conferring resistance through the production of anthranilic acid [
46]. In the present study,
B. toyonensis and
B. cereus isolated from
P. notoginseng seeds exhibited measurable biocontrol effects against root rot. These findings align with numerous reports on the biocontrol potential of seed-derived
Bacillus spp. For instance,
B. velezensis (syn.
B. olimyquefaciens) isolated from surface-sterilized
Urochloa ramosa seeds provided significant protection against
Fusarium infection in seedlings [
47]. Similarly, 6 antagonistic bacterial strains (
B. subtilis,
B. velezensis,
Leuconostoc mesenteroides,
Lactococcus lactis, and
B. amyloliquefaciens) isolated from freshly collected
Solanum nigrum seeds demonstrated effective control of bacterial wilt (
Ralstonia solanacearum) in pepper seedlings, with
B. subtilis showing the highest efficacy. This suggests that seeds from disease-resistant cultivars represent a rich reservoir of antagonistic microorganisms [
48]. Furthermore,
Trichoderma harzianum spore treatment significantly enhanced germination rates and seedling vigor indices in soybean (
Glycine max) and castor (
Ricinus communis), while markedly reducing disease incidence. Quantitative assessments revealed reductions in
Fusarium root rot of soybean (23.3%) and castor wilt (20%) [
49]. These results highlight the potential of such biological formulations as robust, sustainable alternatives to conventional methods, offering scalable solutions for plant disease management while addressing the challenges associated with chemical pesticide use. However, the utilization of beneficial plant endophytes, such as strains of
Bacillus spp., as microbial inoculants presents notable ecological benefits but also necessitates careful risk assessment. While these microbes can enhance plant growth and confer resistance against pathogens, their introduction into natural or agricultural ecosystems may lead to unintended consequences [
50]. Potential risks include disruption of native microbial communities, horizontal gene transfer—particularly involving antibiotic resistance or metabolic genes—and possible adverse effects on non-target organisms, including soil fauna and beneficial microbiota [
51]. Furthermore, the persistence, colonization efficiency, and potential for off-target movement of introduced endophytes require thorough environmental monitoring [
52]. It is imperative to employ comprehensive toxicological evaluations and field-based ecological risk assessments to ensure that the application of such bioagents is both effective and environmentally sustainable, prioritizing strains with well-documented biosafety profiles and minimal ecological impact.
This study has several limitations that should be acknowledged. Firstly, the bacterial sampling was conducted exclusively from Pg seeds within a localized geographical region, which may limit the generalizability of the findings to other populations or ecosystems. Secondly, the functional experiments were performed under controlled in vitro conditions using a single growth environment, which does not fully represent the complex interactions occurring in natural soil–plant systems. Furthermore, the study primarily focused on descriptive characterizations of microbial diversity and antagonistic effects without in-depth mechanistic investigations. The molecular basis underlying the observed plant growth-promoting traits and antifungal activities—such as the identification of specific bioactive compounds, gene regulatory mechanisms, or signal transduction pathways—remains unexplored. To address these limitations, future studies could include multi-region sampling to enhance the representativeness of the endophytic community. Incorporating greenhouse or field experiments would better reflect real-world conditions and strengthen ecological relevance. Moreover, applying transcriptomic, metabolomic, or genetic approaches could help elucidate the functional mechanisms behind the beneficial interactions, such as knock-out mutant assays to validate the key genes involved in antifungal compound production or root colonization. Finally, evaluating the ecological safety and long-term persistence of introduced strains would be critical for potential application in sustainable agriculture.